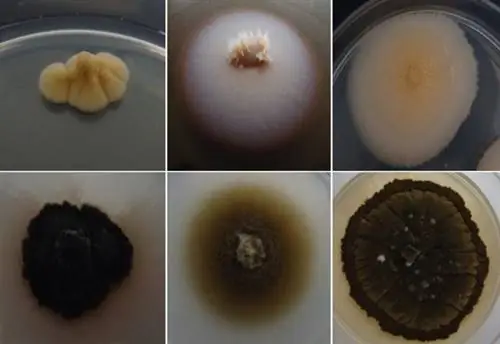
Эминиум луджери

Новая угроза фасадам: Исследователи обнаружили новый вид грибка, который явно может повреждать здания из природного камня. Гриб был найден в соборе Се-Велья в Коимбре, Португалия - объекте Всемирного наследия ЮНЕСКО. Дальнейшие исследования должны теперь показать, насколько широко распространен этот вид и какие памятники все еще могут быть затронуты им.
Будь то пирамиды Гизы или Кёльнский собор: разрушительное действие времени гложет многие культурно значимые памятники - они заметно выветриваются. Помимо вредных погодных воздействий, в этом бесконечном процессе часто виноваты микроорганизмы: бактерии, водоросли, а также грибки могут заметно повреждать здания.
Среди особо упорных врагов фасадов - так называемый черный грибок. Своими гифами они глубоко проникают в камень, вызывая мелкие микротрещины. Они также производят вещества, способствующие коррозии. Но самое проблематичное: грибы чрезвычайно крепкие и выживают даже в самых неблагоприятных условиях. «Это делает их особой проблемой для защитников природы», - пишут исследователи во главе с Жоао Тровао из Университета Коимбры.
Неизвестная вредоносная программа
Именно такой грибок, по-видимому, угрожает объекту Всемирного наследия ЮНЕСКО: 800-летнему собору Се-Велья в Коимбре - единственному собору в романском стиле в Португалии, сохранившемуся практически нетронутым до наших дней. Тровао и его коллеги обнаружили вредителя, исследуя уже заметно разрушающийся известняк из часовни собора Санта-Мария.
Более подробный анализ показал, что сажистый сажистый гриб является ранее неизвестным видом из нового семейства сажистых плесеней (Capnodiales). Исследователи подозревают, что этот вид, называемый Aeminium ludgeri, должен был попасть в Коимбру с камнями, использованными для строительства. Как они сообщают, этот известняк поступает из карьеров в близлежащих регионах Анса и Портуньюш. Материал из этих районов был использован, среди прочего, для строительства «Госпиталя де лос Рейес Католикос» в Сантьяго-де-Компостела в Испании - сегодня это один из старейших отелей в мире.
Непонятная область распространения
До сих пор группа ученых предполагала, что новый гриб встречается только на Пиренейском полуострове. Однако теперь дальнейшие исследования должны показать более точную информацию о его образе жизни и распространении. «Подобные грибы являются одними из главных виновников биокоррозии горных пород. Поэтому крайне важно узнать больше об их биоразнообразии и их биологических, экологических и физиологических характеристиках», - заявляют исследователи.
Только эти знания позволяют разрабатывать инструменты и процессы для лучшей защиты находящихся под угрозой исчезновения памятников от разрушительной силы этих микроорганизмов в будущем.
